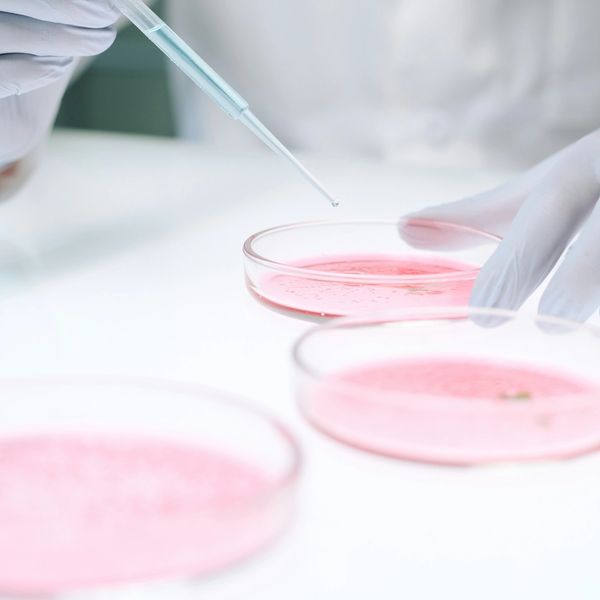

Sarborg




Artificial Intelligence in Healthcare
“Healthcare as a sector, with all the longitudinal data it holds on patients across their lifetimes, is positioned to take advantage of what data science and AI have to offer. From diagnostics, interpretation of lab tests and scheduling appointments, to personalising care, finding cures to conditions, and creating new and innovative solutions to long-standing problems – the opportunities are endless.”
Executive Overview
Sarborg is a technology-driven company that integrates AI agents and mathematical algorithm- based approaches with complementary cybernetics to optimize decision-making processes. Its primary focus is on drug repurposing for pharmaceutical companies, leveraging machine learning and algorithmic strategies to enhance asset portfolio management and improve the probability of success in clinical trials.
The company is led by Dr. Andrew Regan, Chief Executive, who earned a PhD in 2014 for his research on bio-inspired algorithms in financial market forecasting. His thesis, A System to Predict the S&P 500 Using a Bio-Inspired Algorithm, demonstrated a 55.1% accuracy in forecasting next-day (t+1) directional trends of the S&P 500. Since its inception, Sarborg has applied its suite of AI agents, cybernetic algorithms and machine learning capabilities across various sectors, enabling a highly efficient decision-making process throughout its portfolio.
Sarborg was created to address obstacles within the pharmaceutical industry through its platform
Time and Cost
Traditional methods of drug discovery can take significantly longer to identify viable drug candidates, leading to extended development timelines.
Reduced Accuracy and Precision
Human decision-making can be influenced by biases, subjective opinions, or limited perspectives, potentially hindering objective and strategic choices.
Lack of Personalised Medicine
Difficult to tailor treatments to individual patient profiles, leading to less effective and less personalised therapies.
Inefficient Identification of Repurposing Opportunities
Identifying new uses for existing drugs is a complex task which AI can streamline by analysing vast datasets to find potential candidates.
Sarborg’s approach in combining AI agents with cybernetics and machine learning addresses the problems associated with the pharmaceutical sector.
Efficient Decision Making
Our AI agents significantly speeds data analysis to determine which assets can be repurposed.
Enhanced Precision
Our AI agents can efficiently rely on data sets to suitably tailor a treatment to individual patient profiles through detailed analysis.
Reduce Human Error
Significantly reducing human error on both input data accuracy and input selection.
Analyze Complex Data Sets
Our ability to process large amounts of complex data sets can reach a conclusion in an efficient manor to identify candidates.
Reduced Development Timeline
Traditional drug discovery, repurposing, and development timelines typically span 10 to 15 years from initial discovery to market approval. Sarborg disrupts this lengthy process by leveraging its advanced AI agents and cybernetics capabilities to identify high-potential drug assets, indications and combinations in less than six weeks, dramatically reducing the discovery phase.
Once an asset is identified through the Signature Agent, Sarborg utilizes its proprietary technology and multi-agent platform to repurpose it into the most suitable indications, optimizing its therapeutic potential. Following this, the company has the flexibility to either develop the product further or license it out to partners, supported by comprehensive data generated from its findings.
This innovative approach not only accelerates timelines but also maximizes efficiency and commercial potential, positioning Sarborg as a leader in next-generation pharmaceutical innovation.
Traditional Drug Discovery Process
- /001Discovery
- /002Target Validation
- /003Lead Optimisation
- /004Preclinical Development
- /005Phase 1 Clinical Trial
- /006Phase 2 Clinical Trial
- /007Phase 3 Clinical Trial
- /008FDA Application
Sarborg is strategically positioned to capitalize on the rapidly expanding market for drug repurposing and drug discovery, leveraging the increasing demand for innovative therapies and repurposed treatments through utilization of our combined AI agents, cybernetics and machine learning approach to drive growth in this evolving industry.


Dr. Andrew Regan
Dr. Andrew Regan is a Saint Barths based British born polar explorer and entrepreneur. He is the founder and Chief Executive Officer of Corvus Capital.
Dr. Regan sold Hobson Plc in 1996 for £154 million by way of a recommended cash takeover. In the years after the sale of Hobson Plc, Dr. Regan continued to invest in a number of public and private companies and was a founding shareholder in ASOS, Imperial Energy, IB Daiwa and others, which each achieved valuations in excess of $1 billion.
In 2014 he was awarded a PhD for his research in writing and developing a bio-inspired algorithm for forecasting the financial markets. His thesis was “A system to predict the S&P 500 using a bio-inspired algorithm” which forecasted tomorrow’s (t+1) directional trend of the S&P 500 at 55.1% accuracy. This algorithm used a novel parallel processing approach using GPUs. Since then, Dr. Regan has written a number of additional algorithms using an implemented agentic approach.
He is passionate about the polar regions and is an accomplished polar explorer having led a number of expeditions to both the Arctic and Antarctica.
Mr. Craig Wigglesworth

Dr. Hitesh Sanganee
Dr. Hitesh Sanganee has spent over two decades working across all aspects of drug discovery and development. He has supported a myriad of innovations across dermatology, neuroscience, oncology and rare diseases, driven by his mission to see his projects benefit patients. He also remains an active contributor to the life sciences ecosystem, with experience on the board of Apollo LLC (formerly Apollo Therapeutics) as well as the investment committee of life sciences VC, CMS Ventures.
He has been a leader in pursuit of next-generation therapeutics discovery, exemplified as a key instigator in AstraZeneca’s Open Innovation platform, building relationships and sharing resources and knowledge with external researchers leading to funded start-ups across multi-omics, AI and drug discovery.
A recognised thought leader, he was voted among Asia Tech’s Top 100 Innovators in 2021. Hitesh holds a DPhil and BA in Chemistry from the University of Oxford, and an MBA from the University of Cambridge.
Hitesh is currently at Octopus Ventures as a part-time Venture Partner to support the Biotech team, following his previous position as Executive Director and Global Head of Emerging Innovations at AstraZeneca.

Dr. Ben Readhead
Dr. Ben Readhead is the Edson Endowed Professor of Dementia Research at Arizona State University’s Banner Neurodegenerative Disease Research Center. A physician-scientist and computational biologist, his research integrates genomics, biomedical informatics, and systems biology to advance therapeutic discovery for neurodegenerative diseases, with a focus on Alzheimer’s.
His work employs two complementary approaches: disease-centric strategies that construct multiscale network models from multi-omics data to decode causal mechanisms of neurodegeneration, and therapy-centric methods that harness computational drug repositioning to identify novel applications for existing treatments. A key pillar of his research investigates the role of infectious agents such as herpesviruses and the brain microbiome in Alzheimer’s pathogenesis.
Dr. Readhead earned his Bachelor of Medicine & Surgery from the University of Western Australia and has contributed to translational projects across neurology, oncology, and rare diseases.

Dr. David Weston
Dr. David Weston is a seasoned Life Sciences Strategy leader with over 12 years of experience spanning pharmaceuticals, biotechnology, and management consulting. Specializing in R&D innovation, he has spearheaded large-scale transformation initiatives for global biopharma companies, leveraging cutting-edge technologies such as artificial intelligence, quantum computing, and advanced data analytics to accelerate drug discovery and development.
David combines deep scientific expertise with strategic business acumen, holding a PhD in Neuroscience from the University of Cambridge and an Executive MBA from London Business School. His cross-functional background enables him to bridge the gap between scientific innovation and commercial strategy, delivering measurable impact across the life sciences value chain.
AI Agent Based Approach
Agent Based Approach
Sarborg’s AI-Driven Innovation
/// Sarborg is developing specialized AI agents to revolutionize pharmaceutical R&D, drug repurposing, combinations and discovery
Industry Context
/// AI integration in drug discovery is gaining significant traction.
/// Examples of leading AI-driven companies:
/// Insilico Medicine: Uses deep learning for drug candidate identification; valued over $1 billion.
/// Recursion Pharmaceuticals: Focuses on drug repurposing using AI
Sarborg’s Strategic Position:
/// Positions Sarborg at the forefront of pharmaceutical innovation.
/// Aims to enhance drug efficacy, streamline development timelines, and secure robust IP protection.
/// Aligns with industry trends favouring AI integration in drug discovery and development.

Signature Agent: Pinpoint Repurposing
Sarborg’s Signature Agent uses proprietary AI to analyze drug and disease signatures, generating a compatibility score to identify high-potential repurposing, combination, and discovery opportunities across drug portfolios —enabling data-first decisions with unmatched speed.
High-level agent process diagram, further details are available upon execution of NDA
AI-Powered Matching
Proprietary algorithms score drug-disease signature similarities, prioritizing the strongest therapeutic potential.
Scalable Application
Supports both Sarborg’s internal pipeline and client portfolios.
Comprehensive Data Integration
Incorporates genomics, connectivity mapping, and the Sarborg 800 (gold-standard disease signatures) for unbiased alignment.
Actionable Outputs
Shortlisted assets ranked for value unlock, licensing potential, or further development.
Novel Opportunity Detection
Flags overlooked repurposing candidates, synergistic combinations, and de novo discoveries.
Precision-matched signatures drive higher success rates - from discovery to deployment.

Multi-Agent Platform Overview
The illustration displays the multi-agent platform architecture, which constantly evaluates pharmaceutical assets to identify potential opportunities for Sarborg to take forward. These agents include:
Deal-Breaker Agent
Screens for partnership-critical risks.
Landscape Agent
Analyzes therapeutic opportunity maps
Solid-Form IP Agent
Optimizes formulation & patentability.
Commercial & R&D Agents
Assess TAM, pipelines, competition.
IP Landscape Agent
Ensures freedom-to-operate

Step Value Creation Strategy
Sarborg has created a unique structure with three separate arms to maximize value creation…
Client Services
Sarborg partners with pharmaceutical companies to provide AI and cybernetics driven solutions tailored to their business needs, in return for a fee.
These services, delivered through proprietary AI agents, assist in key deliverables such as drug repurposing, asset management, and clinical trial optimization. Our solutions are designed to accelerate decision-making, reduce costs, and enhance R&D outcomes across the pharmaceutical value chain.
Equity Partnerships
Prior to approaching potential partners, Sarborg leverages its proprietary AI agent processes to analyse the drug portfolios of mid-sized, disease-agnostic pharmaceutical companies.
Where strong potential is identified, Sarborg initiates engagement by presenting its findings and outlining possible collaboration pathways. In return, Sarborg selectively takes economic benefits on identified asset opportunities that align with its strategic vision and demonstrate the capacity to benefit from advanced AI-driven capabilities.
Owned Intellectual Property
Using a structured multi-AI agent platform that evaluates a multitude of inputs. Sarborg goes beyond traditional drug repurposing by creating new intellectual property (IP) and superior pharmaceutical products through its proprietary solid-form engineering and formulation strategies. Once IP is generated, Sarborg conducts small animal studies and uses the data derived to out-license assets for royalty and milestone payments.
Client Services
Client Services Overview

Unlocking Value for Clients
Sarborg applies the Signature Agent to pharmaceutical client portfolios, offering fee-based or equity-linked analysis of repurposing potential, data room evaluation, and strategic development insights - including tailored recommendations to enhance IP position and unlock hidden value.
Upload + Align
Client portfolio and data room assets are uploaded, cleaned, and structured for AI interrogation.
Interactive Dashboards
Optional dashboards visualize the analysis in real time, helping teams prioritize opportunities, monitor progress, and integrate AI insights into internal workflows.
AI Agent-Driven Analysis
The Signature Agent identifies repurposing, combination, and discovery opportunities using proprietary drug-disease signature matching and bioinformatics.
Flexible Engagement Models
Collaborations are structured as flat-fee, milestone-based, or equity-linked — depending on portfolio size and strategic scope
Tailored Reporting
Clients receive personalized, insight-rich reports with actionable recommendations — including strategies to strengthen IP, uncover untapped clinical angles, and optimize underused assets
Outcome-Focused
All outputs are designed to unlock hidden value, extend lifecycle potential, and improve ROI across the portfolio.
Tailored Dashboard Creation

The image displays a dashboard developed for a Sarborg client. It includes information on patents that are nearing expiration, those that have been delisted, and those that have been recently approved or added to the database, aiming to provide pharmaceutical companies with a unique solution to identify and evaluate potential candidates for their future portfolio strategies.

The image showcases data related to patient subject information from clinical trials that are either ongoing or recently completed. The data is categorized by key patient demographics, including gender, race, age group, and disease or condition. It can be customized to align with a company’s specific focus or therapeutic area, enabling clients to identify the appropriate patient types for their clinical trials, streamline and enhance patient recruitment processes and gain deeper insights into how different patient groups may respond to a drug.
Equity Partnerships / JV’s
Sarborg employs a unique, AI-first approach to Joint Venture (JV) partnerships
By Investing in these partners, Sarborg:
- /001Enables fully autonomous, AI-Driven decision making (eliminating human intervention bottlenecks)
- /002Secures Sustainable revenue streams tied to partner success
- /003Accelerates sector-wide innovation in pharmaceutical technology
This strategy creates lasting value for partners and shareholders alike while advancing AI adoption across the industry.
Proactive Portfolio Analysis
Prior to any engagement, our proprietary AI agents analyze the drug portfolios of mid-sized, disease-agnostic pharmaceutical companies, identifying high-value opportunities for technological integration.
Structured Economic Alignment
Where strong potential is identified, Sarborg:
/// Presents its findings to demonstrate collaboration potential
/// Selectively negotiates either:
/// Long-term equity stakes in partner companies, or
/// Economic benefits on specific asset opportunities aligned with our strategic vision
Value Creation
These partnerships are exclusively formed with companies that:
/// Have demonstrated compatibility through prior use of Sarborg's client services
/// Exhibit potential for industry leadership via AI-driven strategies
Sarborg's joint venture model identifies high-potential pharma assets, structures flexible equity/revenue partnerships, and accelerates value through autonomous execution - transforming portfolios in weeks, not years.
Portfolio Analysis & Identification
Our proprietary AI agents analyze mid-sized pharma portfolios to:
/// Identify undervalued assets with repurposing potential
/// Score drug–disease matches using the Sarborg 800 signature database
/// Flag high-priority targets for partnership
Present & Structure JV Partnership
Sarborg presents AI-validated opportunities with two pathways:
/// Equity Stake:
Long-term ownership in partner companies
Board-level collaboration on AI-driven R&D
/// Asset-Specific Deal:
Revenue share on repurposed drugs
Milestone payments for validated candidates
Execution & Value Acceleration
Partnerships enable:
/// Autonomous Decision-Making:
AI optimizes development pipelines in real-time
/// Scalable Revenue:
Royalties from partnered assets + equity upside
/// Sector Leadership:
Joint IP creation and accelerated market entry
Owned Intellectual Property
Owned IP: AI Agent Based Approach
Sarborg leverages proprietary AI agents and cybernetics to identify, develop, and partner pharmaceutical assets with unmatched speed, precision, and commercial upside.
/001 Identify
Multi-agent platform identifies repurposing, discovery & combination opportunities using >70 structured criteria — reducing human bias, academic friction & cycle time.
/002 Enhance
Once a candidate has been sourced, through our Cybernetics & solid-form strategies optimize formulation, generate new IP, and prepare for regulatory & partnering readiness.
/003 Out-license
Small animal studies de-risk the asset. Data packages support licensing deals with milestone & royalty potential for Sarborg and its clients.
Agent Driven Identification & IP Generation

Sarborg’s Proprietary Multi-Agent Platform
(currently under development) evaluates drug candidates across IP, market, and clinical dimensions using specific inputs.
Deal-Breaker Agent
Screens for partnership-critical risks.
Landscape Agent
Analyzes therapeutic opportunity maps
Solid-Form IP Agent
Optimizes formulation & patentability.
Commercial & R&D Agents
Assess TAM, pipelines, competition.
IP Landscape Agent
Ensures freedom-to-operate
/// Assets nearing patent expiry or with untapped clinical potential are transformed into differentiated, IP-protected products.
/// Solid-form engineering and novel formulation strategies unlock new, protectable value.
/// Enables market exclusivity, faster regulatory pathways, and strategic positioning for partnering..
From IP Creation to Value Realization
From use of AI Agent to Asset Monetization
Once patented, Sarborg conducts targeted small animal studies to validate efficacy and de-risk development.
Preclinical data package supports partner licensing discussions, enabling pharma to:
/// Advance the asset into Phase II and beyond
/// Pay milestone payments and ongoing royalties
Accelerates timelines
Asset validation achieved in months, not years
Capital-efficient
Avoids need for costly late-stage trials
Scalable model
Repeatable process across multiple assets and indications
Novel solid forms
Such as cocrystals or salts, of identified products, secures intellectual property protection before generic competitors can enter the market, preserving commercial value.
Once the product is protected, Sarborg has the flexibility to license it to the original innovator who has lost exclusivity or to competitors through a market-based pricing or bidding process. This strategy not only maximizes revenue potential but also strengthens Sarborg’s position as a leader in pharmaceutical innovation.
Inflection Points of Value

Feed insights from all steps of the process into other “loops” in a continuously reinforcing system